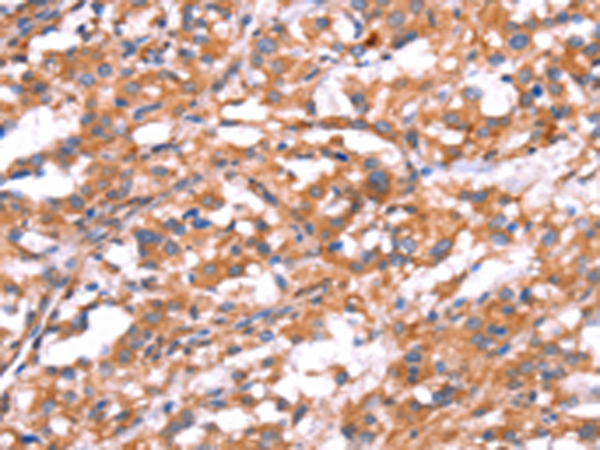

中文名稱: 兔抗GABBR1多克隆抗體
|
Background: |
Gamma-aminobutyric acid (GABA) is the main inhibitory neurotransmitter in the mammalian central nervous system. GABA exerts its effects through ionotropic [GABA(A/C)] receptors, to produce fast synaptic inhibition, and metabotropic [GABA(B)] receptors, to produce slow, prolonged inhibitory signals. The GABA(B) receptor consists of a heterodimer of two related 7-transmembrane receptors, GABA(B) receptor 1 and GABA(B) receptor 2. The GABA(B) receptor 1 gene is mapped to chromosome 6p21.3 within the HLA class I region close to the HLA-F gene. Susceptibility loci for multiple sclerosis, epilepsy, and schizophrenia have also been mapped in this region. Alternative splicing of this gene generates multiple transcript variants. |
|
Applications: |
ELISA, IHC |
|
Name of antibody: |
GABBR1 |
|
Immunogen: |
Synthetic peptide of human GABBR1 |
|
Full name: |
gamma-aminobutyric acid (GABA) B receptor, 1 |
|
Synonyms: |
GB1; GPRC3A; GABABR1; GABBR1-3; dJ271M21.1.1; dJ271M21.1.2 |
|
SwissProt: |
Q9UBS5 |
|
ELISA Recommended dilution: |
1000-2000 |
|
IHC positive control: |
Human thyroid cancer |
|
IHC Recommend dilution: |
25-100 |
購物車
購物車 幫助
幫助
 021-54845833/15800441009
021-54845833/15800441009
